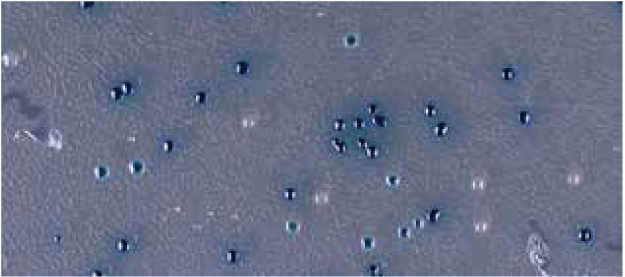

製品・サービス
目次
酵素基質とは
Iris Biotech社がご提供可能な生化学/分子生物学ツールの解説の序章として、酵素と基質の関係、また染色と発色のための基礎知識を掲載しております。
概要
基質とは、生化学分野において酵素によって反応を触媒される化学物質を言います。有機化学分野などにおいては、触媒反応全般においても反応を触媒される化学物質として用いられます。
酵素と基質は特異的に選択され、選択的に反応が起こります。
反応特異性は後述する化学ポテンシャルと立体因子に主に影響され、基質特異性は基質分子の立体構造が酵素のそれと合うかどうかに左右されます。
酵素の働き

図1. 酵素の働き
酵素は生体で起こる化学反応に対して触媒として作用し、反応基質および生成物の化学ポテンシャルを変化させることなく活性化エネルギーの低い別の経路を生み出します。
酵素に対応する基質は非常に高い特異性で認識され、酵素-基質の複合体が形成されたのち、基質は一つもしくは複数の化合物に変換され活性部位より放出されます。
反応中に物理的に検出可能な変化を示す基質は、酵素の活性の有無を評価もしくは定量するのに用いられます。
検出可能な物理的な変化のうち、最も検出が容易なのは吸光(着色)、蛍光および発光です。
応用範囲
分子生物学
多数のクローンおよびサンプルをスクリーニングするのに発色基質は欠かせないツールです。
古典的な例でいえば、組み換えベクターへの遺伝子クローニングの成功を確認するために用いられる青白選択に使われるX-Gal(GBB 1321, 詳しくはこちらをご参照ください)が挙げられます[1]。
最近の例では、遺伝子改変細胞の染色(免疫染色)やレポーター遺伝子の発現の確認などが挙げられます。
図2. 細胞の染色
微生物学
個々の微生物が保有する酵素の活性は非常に特徴的な性質を示し、飲料水や食物、およびその他のサンプルに対しその中に混入する微生物の特定、識別、定量など幅広い応用が考えられます。
例えば、発色性を示す分子であるβ-D-グルクロン酸およびその類縁体 (2.3.17をご参照ください) は飲料水や尿路感染症の細胞に含まれる大腸菌の検出・定量に用いられます。
95%以上の一般的な大腸菌がβ-グルクロニダーゼ活性を持つためです[2]。
生化学および診断
蛍光および発色分子は酵素活性の試験および評価にもっともよく用いられる基質です。
体液中の酵素レベルは健康状態の指標となるため、酵素アッセイは臨床診断に用いられる重要な診断ツールの一つです。
イムノアッセイは健康状態の指標となる様々な代謝産物の検出に用いられます。
色や吸光率の変化によって視覚的に検出することが可能で、ほとんどの研究施設で利用可能な紫外-可視吸光度測定によっても容易に定量も可能です。
これらに対し蛍光物質はより一般的でない設備は必要となりますが、より少量でも検出が可能です。
適切な蛍光/発色分子の選択
蛍光/発色分子を用いた検出方法は現在では一般的に利用されており、各研究施設レベルで、様々な種類の発色/蛍光分子が利用可能です。
分光装置を用いた連続分析を行うためには系が均質な溶液であることが不可欠ですが、反対に細胞内に局在する酵素活性や細菌のコロニーを見るためには、不溶性で弱い拡散力を示す蛍光/発色分子が好まれます。
化合物によっては可視化するために、化学的な処理やpHの調整が必要になります。たとえば、多くのフェノール系の発色分子は塩基性溶媒中でフェノラートとして存在する場合にのみ視覚的な判断が可能になります。
したがって、これらのフェノール系基質は生きた細胞中の酵素反応を観測する実験には適さないと言えるでしょう。
また検出に用いたいパラメータが、系中に存在する他の物質による光吸収や蛍光に影響を受けないような物質を選択することが望ましいといえます。
レポーター酵素
バイオテクノロジーや診断学の分野で目的のタンパク質、ペプチド、オリゴヌクレオチドや代謝産物の存在を可視化するのにいわゆる”レポーター酵素”が用いられます。
この用途によく用いられる酵素として西洋わさびペルオキシダーゼ(Horseradish Peroxidase, HRP)とアルカリホスファターゼ(Alkaline Phosphatase, AP)の2つが挙げられます(これらの酵素に対応する基質は2.1および2.2をご参照ください)。
さらに、これら2つの酵素の遺伝子は特定のゲノム領域がコードする遺伝子の発現を調べるためにゲノムDNAに組み込まれたレポーター遺伝子としても利用可能です。
酵素による免疫測定/免疫染色
一般的にレポーター酵素が最もよく用いられるのは”酵素イムノアッセイ法(Enzyme Immunoassay, EIA)“です。
ターゲットは基質を蛍光/発色分子へと変換するレポーター酵素と結合した一次抗体によって認識されるものが理想的です。
免疫染色は免疫組織化学、免疫細胞化学、フローサイトメトリー、ウェスタンブロッティング、ELISA(Enzyme-linked Immunosorbent Assay)で用いられます。
一次抗体とレポーター酵素の結合を形成するには以下の手法が存在します。

図3. 抗体による免疫染色
📔 実験の手順
A. レポーター酵素と一次抗体を直接結合させる。
B. 一次抗体とレポーター酵素の間にお互いに高い結合能を持つ2分子を組み込み、その分子同士によって結合する(例えば、アビジンとストレプトアビジンがその候補として挙げられます)。
C. レポーター酵素と直接結合した二次抗体によって一次抗体を認識させる。
D. 二次抗体とレポーター酵素の間にお互いに高い結合能を持つ2分子を組み込み、その分子同士によって結合する。その二次抗体の複合体によって一次抗体を認識させる。
核酸の検出
免疫染色と同様、検出対象と特異的に相互作用する分子が抗体によって検出される場合、レポーター酵素は核酸の検出にもお使いいただけます。
目的のDNAまたはRNAは、ハイブリダイゼーションプローブに結合することによって識別されます。
プローブは直接酵素と結合させる、もしくはジゴキシゲニンやビオチンのようなリガンドで標識し、抗ジゴキシゲニン抗体やストレプトアビジンのようなリガンドに対して高親和性のタンパク質を、レポーター酵素に結合させます。
DNA及びRNA断片を同定する典型的な手法として、サザンおよびノーザンブロッティングがあげられます。
対応するmRNAの存在を示すことで、目的の遺伝子が発現した組織を染色する手法も存在します。
結合プローブは蛍光/発色分子または放射性ラベルによってもモニターすることができます。
しかしレポーター酵素は複数の蛍光/発色分子を生成することでシグナルの強度を増し、より高感度の分析を可能にするという利点があります。
レポーター遺伝子
レポーター酵素の別の用途として、レポーター遺伝子の活用が挙げられます。
レポーター遺伝子は、ファージ、ウイルス、培養細胞、植物または動物中の目的の遺伝子の転写調節配列に結合します。
レポーター遺伝子が発現したことによって生体内で起こる変化を識別し、測定が可能という特性を有するため、いくつかのレポーター遺伝子が選択されています。
レポーター遺伝子は多くの場合、目的の遺伝子が細胞、組織または生体中に取り込まれたかまたは発現しているかの指標として使用されます。
よく知られたレポーター遺伝子として、以下の様な物が挙げられます。
- phoA (アルカリフォスファターゼ:AP)
- lacZ (β-ガラクトシダーゼ)
- gusA/uidA (β-グルクロニダーゼ)
- luc (ルシフェラーゼ)
レポーター遺伝子の発現は、蛍光/発色または発光性酵素基質を用いて同時に転写・発現した酵素の活性を測定することによって容易に検出することができます。
お気軽にお問い合わせください。
カタログ記載以外のレポーター酵素の基質も取り扱っております。
リストにない化合物の合成も承っております。詳しくは お問い合わせ ください。
参考文献:
▷ Horwitz, J.P. et al., Substrates for Cytochemical Demonstration of Enzyme Activity. I. Some Substituted 3-Indolyl-β-D-glycopyranosides. J. Med. Chem. 1964; 7(4): 574–5.
▷ Brenner K.P. et al., New medium for the simultaneous detection of total coliforms and Escherichia coli in water. Appl. Environ. Microbiol. 1993; 59: 3534-44.
▷ Mayes J.S. et al., Differential assay for lysosomal alpha-galactosi- dases in human tissues and its application to Fabry‘s disease. Clin. Chim. Acta. 1981; 112: 247-51.
